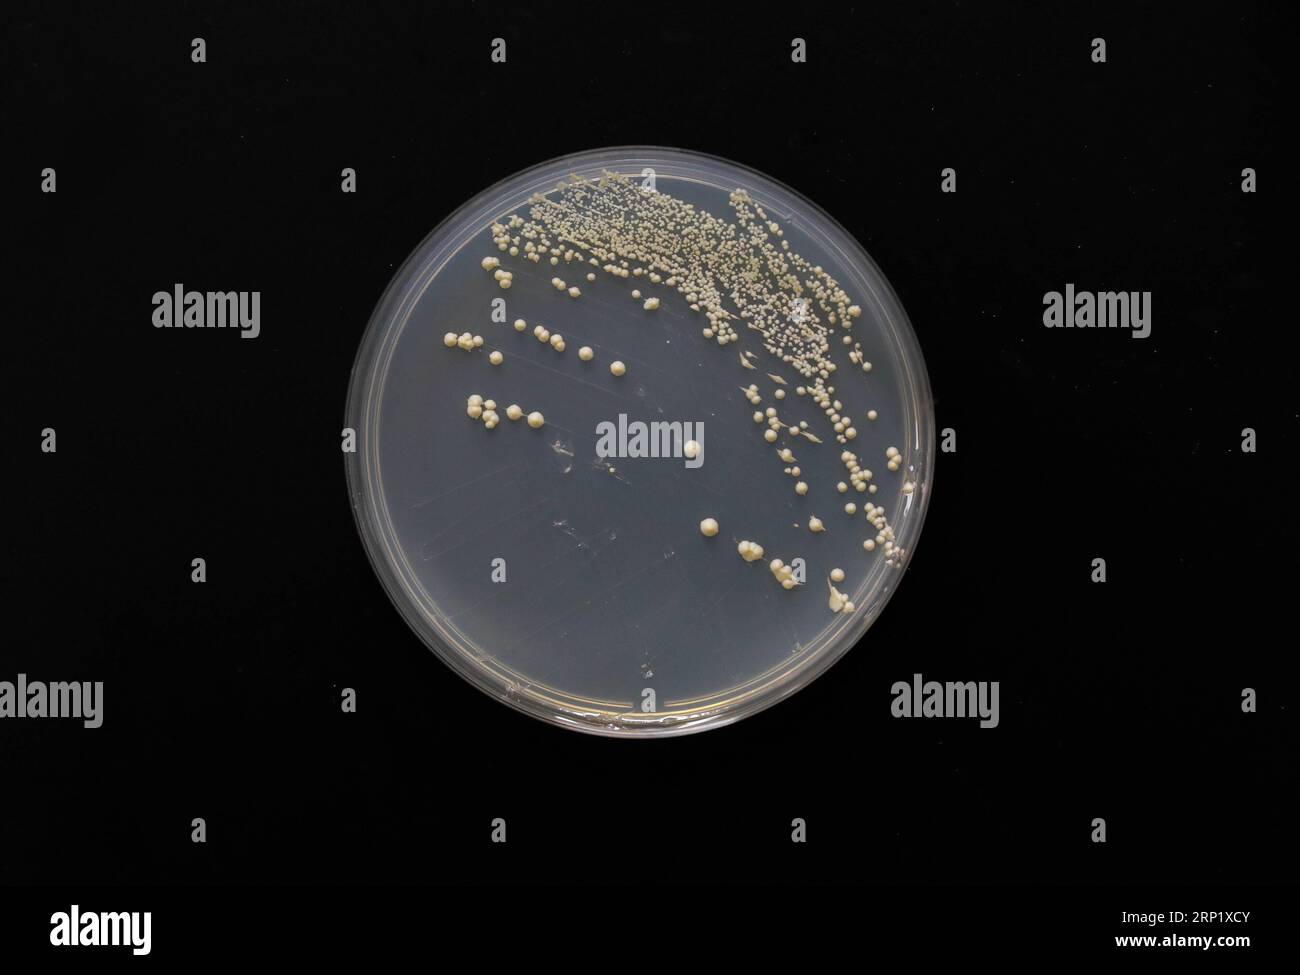
(180805) -- PEKING, 5. August 2018 -- Foto aufgenommen am 31. Juli 2018 zeigt einzelne Chromosomenhefenstamm am Center for Excellence in Molecular Plant Sciences des Shanghai Institute of Plant Physiology and Ecology in Shanghai, Ostchina. Chinesische Wissenschaftler haben eine genetische Operation durchgeführt, um die erste Single-Chromosomen-Hefe zu erzeugen. ) XINHUA FOTO WÖCHENTLICHE AUSWAHL DingxTing PUBLICATIONxNOTxINxCHN Stockfoto

Schnellfilter:
Einzelnes chromosom Stockfotos & Bilder

RF2DHY2E1–Chromosomale Inversion tritt auf, wenn ein einzelnes Chromosom Bruch und erfährt Umgestaltung in sich selbst.

RMPCXFG0–Peking, China. Juli 31, 2018. Foto am Juli 31, 2018 zeigt einzelne chromosom hefestamm am Zentrum für Spitzenleistungen in der Molekularen Pflanzenwissenschaften der Shanghai Institut für Pflanzenphysiologie und Ökologie in Shanghai, China. Chinesische Wissenschaftler haben genetische Chirurgie erste Single - chromosom Hefe zu erstellen durchgeführt. Credit: Ding Ting/Xinhua/Alamy leben Nachrichten
RM2RP1XCY–(180805) -- PEKING, 5. August 2018 -- Foto aufgenommen am 31. Juli 2018 zeigt einzelne Chromosomenhefenstamm am Center for Excellence in Molecular Plant Sciences des Shanghai Institute of Plant Physiology and Ecology in Shanghai, Ostchina. Chinesische Wissenschaftler haben eine genetische Operation durchgeführt, um die erste Single-Chromosomen-Hefe zu erzeugen. ) XINHUA FOTO WÖCHENTLICHE AUSWAHL DingxTing PUBLICATIONxNOTxINxCHN

RMPCFYGT–(180802) - SHANGHAI, August 2, 2018 (Xinhua) - Foto am Juli 31, 2018 zeigt einzelne chromosom hefestamm am Zentrum für Spitzenleistungen in der Molekularen Pflanzenwissenschaften, Shanghai Institut für Pflanzenphysiologie und Ökologie, der Chinesischen Akademie der Wissenschaften in Shanghai, China. Bierhefe, ein Drittel von deren Genom ist sagte Ahnen mit einem Menschen zu teilen, hat 16 Chromosomen. Chinesische Wissenschaftler haben es geschafft, fast alle sein genetisches Material in nur einem Chromosom zu passen zwar nicht die die Mehrheit seiner Funktionen, laut einem Papier Donnerstag auf der Website der Natur veröffentlicht. Q

RFENW32E–Chromosom als eine menschliche Biologie x Struktur mit Dna genetische Informationen als medizinische Symbol für Gen-Therapie oder Mikrobiologie-Genetik-Forschung.

RFKCWC55–Chromosom, computer Abbildung. Chromosomen, die bestehen aus zwei identischen Chromatiden an ein Zentromer (Licht), bestehen aus Desoxyribonukleinsäure (DNA), um Proteine aufgewickelt. Die DNA enthält Abschnitte, Gene genannt, die genetischen Informationen des Körpers kodieren, Bestimmung der Struktur der einzelnen Zelle, Funktion und Verhalten.

RF3D805AJ–Differenz zwischen diploidem und haploidem Chromosom. Zwei Kopien von genetischem Material und ein einziger kompletter Chromosomensatz. Vektorabbildung

RF2X5C91X–DNA-Symbole in einer Zeile. Lebensgenmodell Biocode Genetik Molekül medizinische Symbole. Strukturmolekül, Chromosom. Wirbeln Sie den Kreis mit Locken

RF2PP7H5B–Mitose. Zellteilung. Asexuelle Fortpflanzung. Vorgang einer einzelnen Zelle, die sich durch eine Reihe von Stufen in zwei identische Tochterzellen aufteilt, Includin

RF2D4PD6G–Abstraktes Bild der genetischen Codes DNA. Konzeptbild für den Einsatz als Hintergrund. 3D-Darstellung.

RF2KCY05B–Menschliche Chromosomen (23 + X, Y) Strukturen aus Protein und einem einzelnen DNA-Molekül - Nahaufnahme Ansicht 3D Abbildung

RF3D804YT–Differenz zwischen diploidem und haploidem Chromosom. Zwei Kopien von genetischem Material und ein einziger kompletter Chromosomensatz. Vektorabbildung

RF2K947NF–Menschliche Chromosomen (23 + X, Y) Strukturen aus Protein und einem einzelnen DNA-Molekül - isometrische Ansicht 3D Abbildung

RMT9539A–Single nucleotide Polymorphism (SNP) spielt eine Rolle bei einer Vielzahl von Krankheiten wie Sichelzellenanämie und Mukoviszidose.

RM2EJXFA8–Marietta, GA, USA. Februar 2021, 22nd. Inesh Nayak kriecht GaneshÃs Wohnzimmer familyÃs seines Vaters zur Seite. Inesh, 19, ist meist nonverbal und aufgrund tiefgreifender Entwicklungsherausforderungen nicht in der Lage zu gehen, kann aber auf Händen und Knien in ihrem einstöckigen Zuhause herumlaufen. Bei ihm wurden Trisomie 9 und das CRI du Chat-Syndrom diagnostiziert, beides genetische Chromosomenstörungen. Sitara und ihr Mann Ganesh konnten ihren Sohn zu Hause mit Hilfe von in-Home-Unterstützungen versorgen, die durch das stateÃs Medicaid-Programm finanziert werden, aber die jüngsten Budgetkürzungen könnten die Inesh zwingen, in eine Gruppe hom verlegt zu werden

RMPCFYPM–(180802) - SHANGHAI, August 2, 2018 (Xinhua) - ein Team Mitglied der Molekularbiologe Wang Zhongjun Uhren ein einziges Chromosom Hefestamm durch Elektronenmikroskop am Zentrum für Spitzenleistungen in der Molekularen Pflanzenwissenschaften, Shanghai Institut für Pflanzenphysiologie und Ökologie, der Chinesischen Akademie der Wissenschaften in Shanghai, China, 31. Juli 2018. Bierhefe, ein Drittel von deren Genom ist sagte Ahnen mit einem Menschen zu teilen, hat 16 Chromosomen. Chinesische Wissenschaftler haben es geschafft, fast alle sein genetisches Material in nur einem Chromosom zu passen zwar nicht die Mehrheit seiner Func

RFKCWC57–Chromosom, computer Abbildung. Chromosomen, die bestehen aus zwei identischen Chromatiden an ein Zentromer (Licht), bestehen aus Desoxyribonukleinsäure (DNA), um Proteine aufgewickelt. Die DNA enthält Abschnitte, Gene genannt, die genetischen Informationen des Körpers kodieren, Bestimmung der Struktur der einzelnen Zelle, Funktion und Verhalten.

RMT95398–Es gibt verschiedene Arten von Mutationen. Dazu gehören die Punktmutation, Einfügen, Löschen, Duplizieren, und Inversion. Andere Mutationen sind Chromosom Fusion und Genom Vervielfältigung.

RM2BEH9F7–Chromosomenlöschung. Genlöschung oder Deletion Mutation, ist eine genetische Mutation, bei der ein Teil des Chromosoms oder eine Sequenz von DNA während der DNA-Replikation verloren geht. Gendeletionen sind in der Regel tödlich oder führen zu menschlichen genetischen Störungen und Syndromen.

RF2X5CB2G–Eine einzige Linie, die Helix oder DNA zeichnet. Drahtmodellausführung mit niedrigem Poly. Konzept für Biotechnologie, Wissenschaft, Medizin. Technologie und Innovation in der Gentechnik

RF2X5C79P–DNA-Symbole mit durchgehender einzeiliger Zeichnung. Lebensgenmodell Biocode Genetik Molekül medizinische Symbole. Strukturmolekül, Chromosom. Wirbelnde Lockenform. S

RFGEDFFR–Chromosom X, rot in der Mitte, das Konzept der Infektion, Mutation der Krankheit. 3D illustration

RMW65T47–Wang Zhongjun, Molekularbiologe am Zentrum für Spitzenleistungen in der Molekularen Pflanzenwissenschaften, Shanghai Institut für Pflanzenphysiologie und Ökologie, von C

RM2WWBBEP–Dieser trichromgefärbte Photomikrograph zeigte einen parasitären Entamoeba histolytica trophozoit, der einen einzigen runden Kern enthielt.

RF2XXD610–Meiose, Illustration. Meiose ist der Prozess, bei dem sich eine einzelne Zelle zweimal teilt und vier haploide Tochterzellen bildet.

RMDXAKNE–Welt Downsyndrom Tag (WDSD) wird am 21. März beobachtet. An diesem Tag, Menschen mit Down-Syndrom und diejenigen, die Leben und arbeiten mit ihnen in der gesamten Welt organisieren und Teilnahme an Aktivitäten und Veranstaltungen zur Sensibilisierung der Öffentlichkeit und erstellen ein einzelnes. Das Datum für WDSD wird am 21. Tag des 3. Monats wurde ausgewählt, um die Einzigartigkeit der Verdreifachung (Trisomie) des 21. Chromosoms bedeuten das Down-Syndrom verursacht. WDSD wurde erstmals im Jahr 2006 in vielen Ländern auf der ganzen Welt beobachtet und Down-Syndrom Association Singapore ins Leben gerufen und Gastgeber die WDSD Website von 2006 bis 2010 im Auftrag von D

RF2C39R31–Kreative Vektor-Illustration von seltenen Chromosomenstörung Awareness Week Konzept Poster Design

RFGEDFD8–X-Chromosom auf blauem Hintergrund mit Fokuseffekt, wissenschaftliches Konzept. 3D illustration

RMD0N4W5–Ein Telomer ist Region DNA-Sequenz Ende Chromosom. Ihre Funktion ist schützen enden Chromosom degradating. Hier sind sie sichtbar

RMW65WFP–Wang Zhongjun, Molekularbiologe am Zentrum für Spitzenleistungen in der Molekularen Pflanzenwissenschaften, Shanghai Institut für Pflanzenphysiologie und Ökologie, von C

RF2XXD61A–Meiose, Illustration. Meiose ist der Prozess, bei dem sich eine einzelne Zelle zweimal teilt und vier haploide Tochterzellen bildet.

RMDXAKNR–Welt Downsyndrom Tag (WDSD) wird am 21. März beobachtet. An diesem Tag, Menschen mit Down-Syndrom und diejenigen, die Leben und arbeiten mit ihnen in der gesamten Welt organisieren und Teilnahme an Aktivitäten und Veranstaltungen zur Sensibilisierung der Öffentlichkeit und erstellen ein einzelnes. Das Datum für WDSD wird am 21. Tag des 3. Monats wurde ausgewählt, um die Einzigartigkeit der Verdreifachung (Trisomie) des 21. Chromosoms bedeuten das Down-Syndrom verursacht. WDSD wurde erstmals im Jahr 2006 in vielen Ländern auf der ganzen Welt beobachtet und Down-Syndrom Association Singapore ins Leben gerufen und Gastgeber die WDSD Website von 2006 bis 2010 im Auftrag von D

RF2C39WGY–Kreative Vektor-Illustration von seltenen Chromosomenstörung Awareness Week Konzept Poster Design

RFGEDFNM–X-Chromosom auf grauem Hintergrund. mit Schärfentiefe-Effekt, wissenschaftliches Konzept. 3D illustration

RMD0N5FK–Ein Telomer ist Region DNA-Sequenz Ende Chromosom. Ihre Funktion ist schützen enden Chromosom degradating. Hier sind sie sichtbar

RMW65HAA–Wang Zhongjun, Molekularbiologe am Zentrum für Spitzenleistungen in der Molekularen Pflanzenwissenschaften, Shanghai Institut für Pflanzenphysiologie und Ökologie, von C

RF2XXD622–Meiose, Illustration. Meiose ist der Prozess, bei dem sich eine einzelne Zelle zweimal teilt und vier haploide Tochterzellen bildet.

RMDXAKP0–Welt Downsyndrom Tag (WDSD) wird am 21. März beobachtet. An diesem Tag, Menschen mit Down-Syndrom und diejenigen, die Leben und arbeiten mit ihnen in der gesamten Welt organisieren und Teilnahme an Aktivitäten und Veranstaltungen zur Sensibilisierung der Öffentlichkeit und erstellen ein einzelnes. Das Datum für WDSD wird am 21. Tag des 3. Monats wurde ausgewählt, um die Einzigartigkeit der Verdreifachung (Trisomie) des 21. Chromosoms bedeuten das Down-Syndrom verursacht. WDSD wurde erstmals im Jahr 2006 in vielen Ländern auf der ganzen Welt beobachtet und Down-Syndrom Association Singapore ins Leben gerufen und Gastgeber die WDSD Website von 2006 bis 2010 im Auftrag von D

RF2C39XRE–Kreative Vektor-Illustration von seltenen Chromosomenstörung Awareness Week Konzept Poster Design

RFGP43AA–Chromosom X, Grün in der Mitte, das Konzept der Infektion, Mutation, Krankheit, mit Focus Effekt. 3D illustration

RMD0N6YN–Ein Telomer ist Region DNA-Sequenz Ende Chromosom. Ihre Funktion ist schützen enden Chromosom degradating. Hier sind sie sichtbar


























































